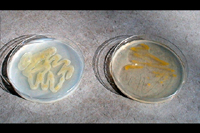

Stewart's wilt (Syn. Stewart's disease, Stewart's bacterial wilt)
Erwinia stewartii (Syn.
Pantoea stewartii)
corn (Zea mays); other secondary host plants can be infected artificially by inoculation
Author
Jerald K. Pataky
University of Illinois

Erwinia stewartii. |
Symptoms and Signs
Two phases of Stewart's wilt occur on corn. The
seedling wilt phase occurs when young plants are infected systemically (Figure 2). The
leaf blight phase occurs when plants are infected after the seedling stage (Figure 3). Infection occurs in plant tissues that are wounded during feeding by an insect (Figure 4), the corn flea beetle (Chaetocnema pulicaria) (Figure 5). The corn flea beetle is the overwintering host and vector of
Erwinia stewartii, the bacterium that causes Stewart's wilt.

Figure 2 |

Figure 3 |

Figure 4 |

Figure 5 |
Initial symptoms are similar for both phases of the disease. Leaf tissue surrounding feeding wounds initially become water-soaked (Figure 6). Pale-green to yellow linear streaks with irregular or wavy margins develop parallel to leaf veins (Figure 7). These lesions become necrotic with age and may extend the entire length of the leaf on susceptible cultivars. When plants are infected systemically, symptoms appear on new leaves emerging from the plant whorl (Figure 8), and cavities may form in the stalks near the soil line (Figure 9). Bacteria spread throughout the vascular system of systemically infected plants and occasionally infect kernels. A range of reactions to Stewart's wilt occurs among different cultivars of corn (Figure 10). In resistant cultivars, symptoms usually are limited to within 2 to 3 cm (1 to 2 in.) surrounding flea beetle feeding wounds (Figure 6), and systemic infection occurs rarely, if ever. If infection occurs when seedlings are emerging, main stalks can be killed which may result in profuse growth of tillers (Figure 11). Although it has not been demonstrated experimentally, main stalk death probably results from infection of the primary growing point when flea beetles transmit
E. stewartii while feeding on emerging coleoptiles (the tissue sheathing the first true leaf) or very young seedlings.

Figure 6 |

Figure 7 |

Figure 8 |

Figure 9 |

Figure 10 |

Figure 11 |
Foliar symptoms of the leaf blight phase are similar to those of the seedling wilt phase. Chlorotic or necrotic tissues may extend the entire length of leaves, or symptoms may be limited to a few centimeters (inches) depending on the susceptibility of the cultivar (Figure 3). Premature leaf death due to Stewart's wilt may predispose the weakened plant to stalk rot resulting in reduced yields.
Multiple, coalesced lesions of northern corn leaf blight (NCLB), caused by the fungus
Exserohilum turcicum, may resemble necrotic leaf symptoms of the seedling wilt or the leaf blight phases of Stewart's wilt (Figure 12). Plants suffering from drought stress, insect injury, nutritional deficiencies (such as iron deficiency) or genetic stripe (a non-infectious disorder) also may have foliar symptoms that are similar to the seedling wilt or leaf blight phase of Stewart's wilt. A simple microscopic examination of leaf tissue for bacterial ooze (Figure 13) can differentiate Stewart's wilt from non-bacterial disorders with similar symptoms. Differentiating Stewart's wilt from Goss's wilt, caused by
Clavibacter michiganensis subsp.
nebraskensis, may require additional tests.

Figure 12 |

Figure 13 |
Pathogen Biology
Causal organism
Erwinia stewartii is a facultative anaerobic, Gram-negative, nonflagellate, nonspore-forming, rod-shaped bacterium. Culture medium affects colony color and growth (Figure 14). Pathogenicity of
E. stewartii is related to the production of extracellular polysaccharides that contribute to occlusion (plugging) of xylem vessels and symptom development. Pathogenicity and the appearance of water-soaked symptoms also require the hypersensitive response and pathogenicity (hrp) and water-soaking (wts) gene cluster which is substantially homologous with the
hrp gene cluster found in
Erwinia amylovora, the bacterium that causes fire bight.
Figure 14 |
Taxonomy
Erwinia stewartii is closely related to other bacteria in the
Erwinia herbicola-Enterobacter agglomerans complex. The taxonomy of this pathogen was debated throughout the first half of the 20th century until D.W. Dye proposed
Erwinia stewartii in 1963. Prior to this, the bacterium was named:
Pseudomonas stewartii,
Bacterium stewartii,
Aplanobacter stewartii,
Bacillus stewartii,
Phytomonas stewartii,
Xanthomonas stewartii, or
Pseudobacterium stewartii. Recently, the nomenclature of the genus
Erwinia was modified based on chemotaxonomic and molecular methods, however the taxonomic complexity of this group has not been completely resolved, and a dual system is used presently. The genus
Pantoea was proposed for some strains of the
Erwinia herbicola-Enterobacter agglomerans complex, including E. stewartii, however separation of this group from other
Erwinia species is not fully supported by some methods, such as with 16S RNA sequence analysis. Thus, the pathogen is to be referred to as
Pantoea stewartii and
Erwinia stewartii.
In comparison to other bacteria in this group,
E. stewartii appears to be a relatively homogeneous organism that is adapted to surviving primarily in two hosts, corn and the corn flea beetle,
Chaetocnema pulicaria. By occupying these two specialized niches, populations of
E. stewartii may have been selected for much greater similarity than non-specialist
Erwinias, such as
E. herbicola and
E. carotovora, which are ubiquitous in nature and much more phenotypically diverse than
E. stewartii.
Disease Cycle and Epidemiology

Pathogen survival and dissemination
Erwinia stewartii survives primarily in two hosts, corn and the corn flea beetle,
Chaetocnema pulicaria. The bacterium is transmitted almost exclusively by corn flea beetles. There are no known examples of widespread, prolonged occurrences of Stewart's wilt in the absence of this insect. Charlotte Elliot and F. W. Poos tested over 28,500 insect specimens representing 94 species and 76 genera for
E. stewartii and concluded that
C. pulicaria was the only species of importance in harboring the bacterium and spreading the disease. The bacterium occasionally has been isolated from
Chaetocnema denticulata and other insects, but none is a vector of importance under field conditions.
Erwinia stewartii overwinters in the alimentary tract of corn flea beetles. These insects emerge from hibernation in the spring when soil surface temperatures reach about 18° to 21°C (65° to 70°F). Flea beetles transmit
E. stewartii while feeding on corn. The bacteria are unable to spread from plant to plant without the vector. Although bacteria are present in regurgitated material and in feces of
C. pulicaria, the most probable mode of infection appears to be from fecal contamination of feeding wounds. Two or more summer generations of flea beetles develop during the growing season. The first summer generation peaks about mid-June and subsequent generations occur about four or more weeks later. Two cycles of Stewart's wilt infection coincide with flea beetle population dynamics. The first cycle of Stewart's wilt is the most damaging because seedlings are infected by
E. stewartii transmitted by the overwintering generation of flea beetles. The second cycle of infection occurs when the bacteria are transmitted by the first summer generation of the insect. The second cycle of infection usually causes the leaf blight phase of Stewart's wilt in field corn, but it can cause the seedling wilt phase in late-planted sweet corn. Subsequent generations of flea beetles acquire the bacterium from infected plants and become the overwintering population.
Although
E. stewartii can be seed-borne, seed transmission plays an insignificant role in the epidemiology of Stewart's wilt in North America. Similarly, the chance of introducing
E. stewartii into other regions of the world by seed transmission is virtually zero when seed is produced on resistant inbred seed parents. The susceptibility of the seed parent plant greatly affects whether seed harbors
E. stewartii. If seed parent plants are infected systemically during the seedling wilt phase of the disease, seed may be infected with
E. stewartii. If the leaf blight phase of Stewart's wilt occurs but seed parent plants are not infected systemically, seed infection is extremely unlikely. Rates of seed transmission were overestimated for nearly 60 years because initial research on seed transmission of
E. stewartii in the first half of the 20th century did not consider reactions of seed parent plants and/or the occurrence of vectors. Based on recent research, rates of transmitting
E. stewartii in seed appear to be about 1 in 50,000 for seed produced on systemically infected, susceptible seed parent plants and 1 in 20,000,000 for seed produced on resistant plants with symptoms of the leaf blight phase of Stewart's wilt.
Geographic Distribution
Although the disease has been reported infrequently from various parts of the world, the bacterium has never become established outside of the region of North America where the vector occurs. Over 60 countries place quarantine restrictions on corn seed to prevent the introduction of
E. stewartii. In the United States, Stewart's wilt is endemic in the mid-Atlantic states, the Ohio River Valley, and the southern portion of the Corn Belt (Figure 15). The occurrence of Stewart's wilt in other eastern and midwestern states and in portions of Canada coincides with the occurrence of corn flea beetles.

Figure 15 |
Stewart's wilt forecast
Stewart's wilt was one of the first plant diseases for which a disease forecast system was developed. By comparing maps of winter temperatures and Stewart's wilt in the early 1930s, N.E. Stevens developed a system to predict Stewart's wilt based on a winter temperature index. Fifteen years later, G. H. Boewe modified Steven's forecast to more accurately predict the leaf blight phase of Stewart's wilt (Table 1). The Stevens-Boewe forecast can be simplified further by dividing the winter temperature index by 3 to approximate the average winter temperature. If the average daily temperature for December through February is above freezing, >1°C (33°F), flea beetles survive and Stewart's wilt is likely to be severe on susceptible hybrids. If the average daily temperature is less than -3°C (27°F), flea beetles are not likely to survive, and it is unlikely that Stewart's wilt will be severe. The Stevens-Boewe system is an imperfect predictor, but it can be used as a guideline to advise growers of the potential for Stewart's wilt on susceptible varieties (Figure 16). Severe outbreaks of Stewart's wilt in the Midwest and eastern United States in the early-1930s, early-1950s, and 1990s followed winters that were among the warmest of the 20th century.
Table 1. Stevens-Boewe forecast for Stewart's wilt. Developed by N. E. Stevens in the 1930s and revised in the 1940s by G. H. Boewe at the Illinois Natural History Survey, University of Illinois. |
|
Winter Temp index |
Seedling wilt phase |
Leaf blight phase |
100 or more | destructive | severe |
90 to 100 | light to severe | severe |
85 to 90 | nearly absent | moderate |
80 to 85 | nearly absent | light |
below 80 | nearly absent | trace |
Winter temperature index = sum of average temperature (°F) for December, January, and February. |

Figure 16 |
Disease Management
Management of Stewart's wilt of corn
Various disease control tactics can be integrated to manage Stewart's wilt, including: host resistance, protection/eradication, and exclusion.
Host resistance
Throughout North America, Stewart's wilt is controlled effectively by planting resistant corn hybrids. Resistance restricts the movement of
Erwinia stewartii in the vascular system of plants and prevents plants from becoming infected systemically. Thus, levels of resistance affect the frequency of systemically infected plants (Figure 17). Most field corn hybrids are highly to moderately resistant to Stewart's wilt, whereas reactions of sweet corn hybrids range from resistant to highly susceptible. Stewart's wilt resistance is inherited relatively simply and can be selected easily. Plant breeders and pathologists typically inoculate plants with
E. stewartii or rely on natural infection to select plants with mild symptoms (Figure 18). If a hybrid has a level of resistance that prevents systemic infection, economic damage (e.g., yield losses) is rare (Figure 19).

Figure 17 |

Figure 18 |

Figure 19 |
Protection/Eradication
In some situations, growers prefer to plant hybrids with moderate or susceptible reactions to Stewart's wilt because these corn hybrids are superior for other important characteristics. For example, many fresh market sweet corn growers plant early-maturing hybrids that are moderately susceptible or susceptible so that crops can be harvested early when prices are high. In this situation, Stewart's wilt can be managed by controlling corn flea beetles. Seed treatment insecticides (e.g., clothianidin, imidicloprid, thiamethoxam) protect plants from infection by killing the insect vector before the bacterium is transmitted (Figure 20). Insecticides applied in-furrow at planting or insecticides applied as foliar treatments after seedlings emerge also control flea beetles, although the ability of in-furrow or foliar insecticides to manage Stewart's wilt has been somewhat more erratic than seed treatment insecticides.

Figure 20 |
Exclusion
Infected seed is unimportant in the epidemiology of Stewart's wilt in areas where the disease is endemic; however, the bacterium can be excluded from areas where it does not already occur by ensuring that seed is pathogen-free. The probability of transmitting
E. stewartii in seed is extremely low, but over 60 countries place some type of quarantine restriction on corn seed to prevent the introduction of
E. stewartii.
Producing seed in areas where Stewart's wilt does not occur ensures that
E. stewartii will not be introduced on seed. For example, most sweet corn seed is produced in Idaho where Stewart's wilt normally does not occur. In the Midwest where most field corn seed is produced, visual inspections of seed production fields for symptoms of systemic Stewart's wilt infection can provide a qualitative assessment of whether seed may harbor
E. stewartii. The probability of introducing
E. stewartii on seed is nearly zero except when seed parent plants are infected systemically. When plants are systemically infected, an approved seed health test can be used to detect
E. stewartii-infected seed. A seed health test based on an enzyme-linked immunosorbent assay (ELISA) and an appropriately large sample of seed has been approved by the United States Department of Agriculture (USDA) National Seed Health System to ensure at a known probability that
E. stewartii-seed infection is below an accepted threshold (Figure 21).

Figure 21 |
Significance
Economic Significance
Stewart's wilt has little effect on yield of resistant field corn hybrids grown in North America, but it can substantially reduce yields of susceptible sweet corn hybrids. Stewart's wilt also can economically impact seed trade because of quarantine restrictions and/or costs associated with breeding for resistance.
In field corn, yield losses due to Stewart's wilt have been inconsequential in North America for the past 50 years except for a few, localized sporadic outbreaks. The minimal economic impact of Stewart's wilt on field corn is primarily due to adequate levels of resistance in corn hybrids that are grown where the disease occurs. Nevertheless, some early-maturing field corn lines are moderately susceptible. Prior to the development of resistant hybrids, Stewart's wilt caused notable economic losses, particularly during epidemics in the early 1930s.
In sweet corn, economic losses continue to be notable because susceptible or moderately susceptible hybrids are grown periodically in areas where flea beetles occur. Yield losses in sweet corn are affected by the level of resistance of the hybrid and by the growth stage at which plants are infected (Table 2). Yield is not adversely affected or losses are minimal in resistant and moderately resistant hybrids; however, losses frequently range from 40% to 100% when susceptible sweet corn hybrids grown under epidemic conditions are infected prior to the 5-leaf stage. Yield losses in sweet corn are related to systemic infection. Yield is reduced about 0.8% for each 1% incidence of plants infected systemically as seedlings (Figure 22).
Table 2. Potential effects of Stewart's wilt on yield losses in sweet corn1. |
| |
Growth stage when infected |
Hybrid reaction |
3- to 5-leaf |
5- to 7-leaf |
7- to 9-leaf |
Resistant (R) | 0% | 0% | 0% |
Moderately resistant (MR) | 0-30% | 0% | 0% |
Moderately susceptible (MS) | 10-40% | 0-20% | 0% |
Susceptible (S) | 40-100% | 15-35% | 3-15% |
Prior to 3-leaf stage, main stalks may be killed. |
1Suparyono & Pataky.1989. Plant Dis. 73:339-345. |

Figure 22 |
Stewart's wilt also can have an economic impact on seed trade as a result of phytosanitary regulations imposed by trading partners. Phytosanitary regulations for
Erwinia stewartii primarily affect seed commerce by preventing seed from being exported or by creating additional costs for phytosanitary inspections prior to export. During recent epidemics in the 1990s, Stewart's wilt was a significant economic issue for the corn seed industry because of the logistics of trading and exchanging large volumes of field corn seed throughout the world. Stewart's wilt also creates indirect costs for seed producers because resources must be used to screen germplasm and breed corn for Stewart's wilt resistance in order to develop hybrids that efficiently and effectively control the disease.
Historical Significance
Our present understanding of Stewart's wilt is based on a compilation of discoveries by several plant pathologists, entomologists, and geneticists who added to existing knowledge that often included erroneous facts or misconceptions. This evolution of knowledge continues today as researchers learn more about the bacterium, its insect vector, and the genetics of host resistance.
In the late 1880s, a new bacterial disease of corn was described from fields in southern Illinois by T. J. Burrill, whose work on fire blight was instrumental in establishing the concept that plant diseases could be caused by bacteria. Burrill and an entomologist, S. A. Forbes, associated these symptoms with dry weather, tissues from which bacteria were observed, and large populations of chinch bugs. Despite isolating bacteria from symptomatic plants and insects, Burrill was unable to complete Koch's postulates. Although Burrill's description of plants suffering from this affliction included many symptoms that are not attributed currently to Stewart's wilt, Burrill probably was the first to study Stewart's wilt.
In 1895, F. C. Stewart observed a bacterial wilt of sweet corn on Long Island, New York. Stewart gave an accurate account of the symptoms, isolated the bacterium, and reproduced the symptoms by inoculating sweet corn. Stewart believed the disease was confined to sweet corn, and, thus, was different from the disease that Burrill described from field corn. Stewart sent a culture of the bacterium to E. F. Smith who in 1898 described and named it
Pseudomonas stewartii. Smith later supported Stewart's suggestion that the bacterium was disseminated readily by seed. Twenty-five years later in 1923, F. V. Rand and Lillian Cash implicated the corn flea beetle,
Chaetocnema pulicaria, as the primary vector responsible for the mid-season spread of the leaf blight phase of the disease. The ability of
Erwinia stewartii to overwinter primarily in the insect vector rather than in seed was established by F. W. Poos and Charlotte Elliott in 1934.
In the midst of severe epidemics in the early-1930s, Stewart's wilt was largely responsible for the development and enthusiastic acceptance of the first widely-grown, single-cross corn hybrid, 'Golden Cross Bantam.' 'Golden Cross Bantam' was among the first great economic contributions of hybrid corn. In 1923, Glenn Smith, a USDA scientist working in the Department of Botany and Plant Pathology at Purdue University (Figure 23), began inbreeding lines from a popular, open-pollinated sweet corn cultivar, 'Golden Bantam.' Like many early-maturing sweet corn cultivars derived from Northern Flint corn, 'Golden Bantam' was extremely susceptible to Stewart's wilt (Figure 24). In 1930, Smith tested his first set of 'Golden Bantam' hybrid crosses in the midst of one of the most destructive epidemics of Stewart's wilt ever experienced in northern Indiana. Two of Smith's inbred lines, P39 and P51 derived from two different versions of 'Golden Bantam,' combined to produce a single-cross hybrid that was resistant to Stewart's wilt (Figure 25). Following a second year of successful performance during another Stewart's wilt epidemic in 1931, the hybrid was named 'Golden Cross Bantam.' Within a few years after it was released in 1932, 'Golden Cross Bantam' had virtually revolutionized the sweet corn canning industry and 70 to 80% of all sweet corn canned in the US was Glenn Smith's Stewart's wilt-resistant hybrid.

Figure 23 |

Figure 24 |

Figure 25 |
Fifteen years after his remarkable accomplishment, Smith modestly commented on his work in The Hybrid Corn Makers, "Our project was well planned, and I just carried out the work as best I could. Some of it, to be sure, was monotonous, but take the job as a whole and it has been a lot of fun. I shall never cease to be thankful that we had that epidemic of bacterial wilt from 1930 until 1933, for without that bit of good luck we might never have discovered the possibilities of Golden Cross Bantam." In addition to Stewart's wilt resistance, the "possibilities of Golden Cross Bantam" included uniformity that was unknown among sweet corn cultivars prior to the development of hybrids. Because it was a single-cross hybrid produced from two inbred parents, 'Golden Cross Bantam' was more uniform than open pollinated cultivars or the three-way and double-cross field corn hybrids of the 1930s which were produced from three or four inbred parents. This new variety of "hybrid corn" was extremely popular among sweet corn processors well into the 1950s, and sweet corn inbred lines with P39 and P51 in their backgrounds continue to be used as parents of sweet corn hybrids grown today. Resistance to Stewart's wilt also continues to be a valuable attribute of sweet corn hybrids grown in areas where the disease occurs in order to prevent notable reductions in yield (Figure 26).

Figure 26 |
Stewart's wilt was again epidemic in North America in the early 1950s and in 1992, 1995, and 1998-2000 following unusually warm winters and/or during summer droughts. These epidemics prompted a resurgence of applied research on host resistance, insecticidal control, flea beetle population dynamics, and seed transmission.
Erwinia stewartii also has recently been a model organism for basic biological research on the genetics and biochemistry of pathogenicity and the role of quorum-sensing regulation of gene expression.
Selected References
Boewe, G.H. 1949. Late season incidence of Stewart's disease on sweet corn and winter temperatures in Illinois, 1944-1948. Plant Dis. Reporter 33:192-194.
Braun, E.J. 1982. Ultrastructural investigation of resistant and susceptible maize inbreds infected with
Erwinia stewartii. Phytopathology 72:159-166.
Crabb, A.R. 1947. The Hybrid-Corn Makers: Prophets of Plenty. Rutgers University Press, New Brunswick, NJ.
Dodd, J. L. 1980. The role of plant stress in the development of corn stalk rots. Plant Dis. 64:533-537.
Freeman, N.D. and J. K.Pataky. 2001. Levels of Stewart's wilt resistance necessary to prevent reductions in yield of sweet corn hybrids. Plant Dis. 85:1278-1284.
Lamka, G.L., J.H. Hill, D.C. McGee , and E.J. Braun. 1991. Development of an immunosorbent assay for seedborne
Erwinia stewartii in corn seeds. Phytopathology 81:839-846.
Pataky, J.K. and R. Ikin. 2003.
The risk of introducing
Erwinia stewartii in maize seed: a pest risk analysis prepared for the International Seed Federation, Nyon, Switzerland.
Pataky, J. K., P.M. Michener, N.D. Freeman, R.A. Weinzierl, and R. Teyker. 2000.Control of Stewart's wilt in sweet corn with seed treatment insecticides. Plant Dis. 84:1104-1108.
Pepper, E. H. 1967. Stewart's bacterial wilt of corn. Monograph 4. American Phytopathological Society. St. Paul, MN.
Smith, G. D. 1933. Golden Cross Bantam. USDA Agr. Circ. 268. 12 p
Stevens, N. E. 1934. Stewart's disease in relation to winter temperatures. Plant Dis. Reporter 18:141-149.
Stewart, F. C. 1897. A bacterial disease of sweet corn. N.Y. Agric. Exp. Sta. Bull. 130:422-439.
